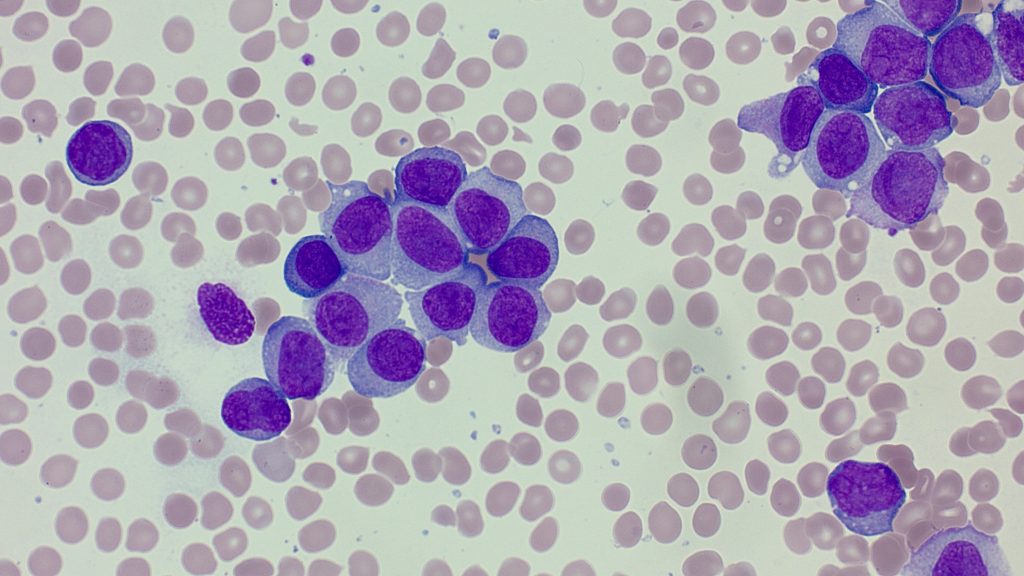
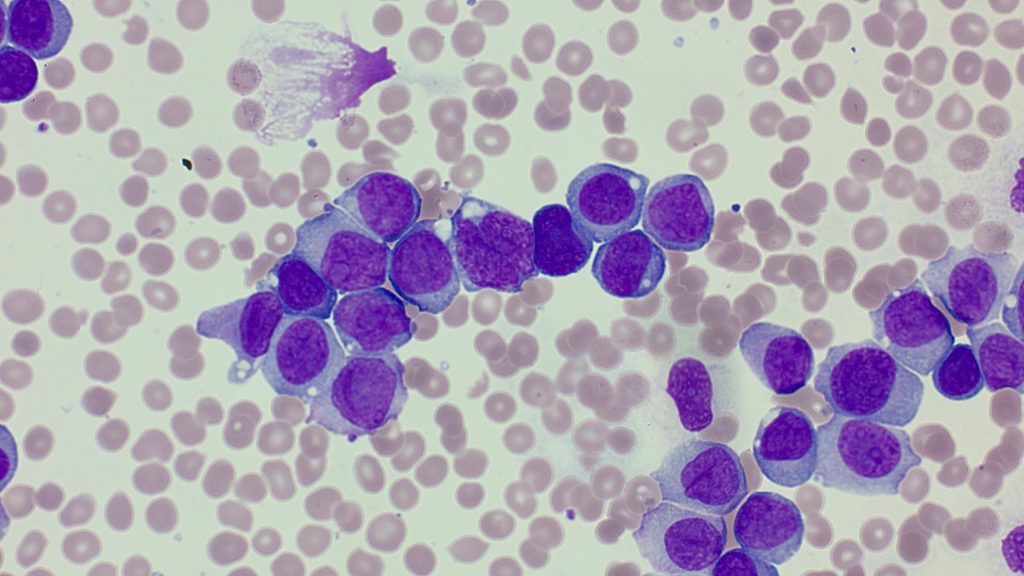
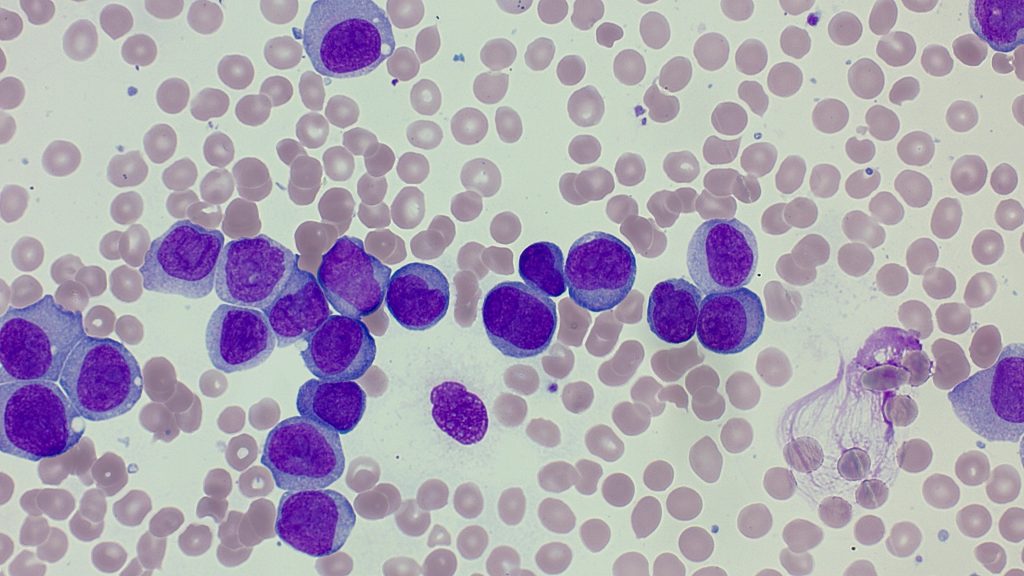
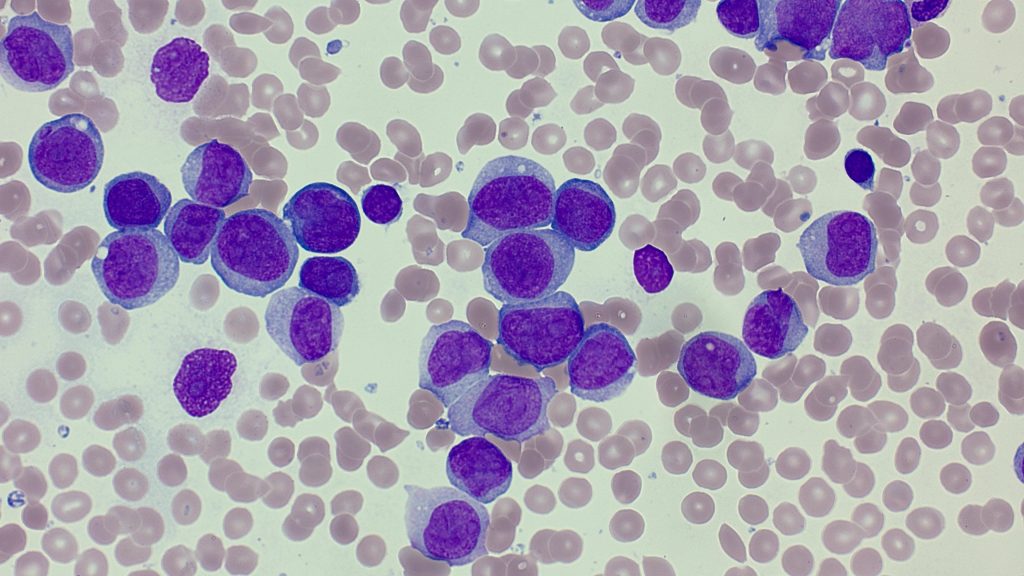
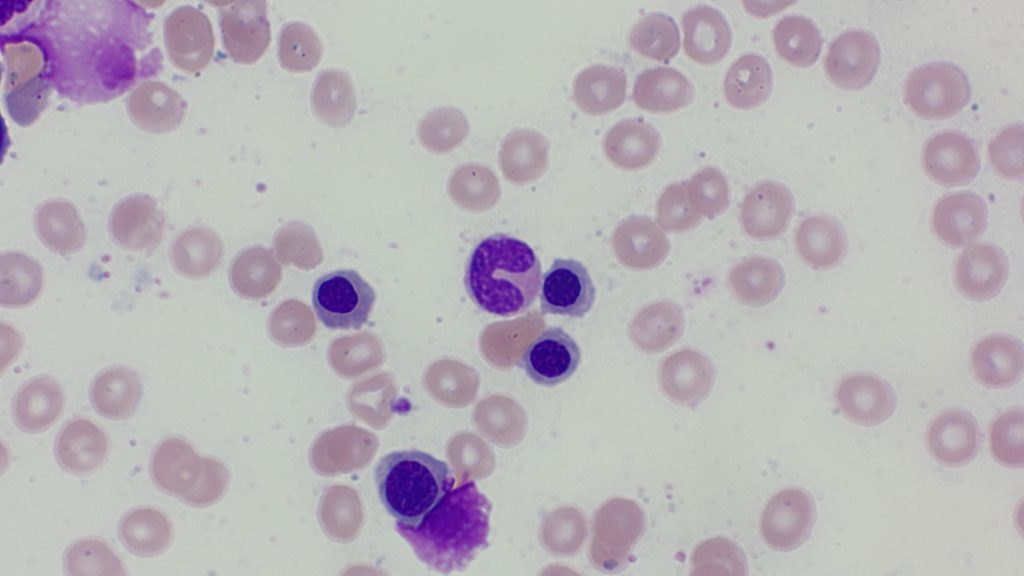
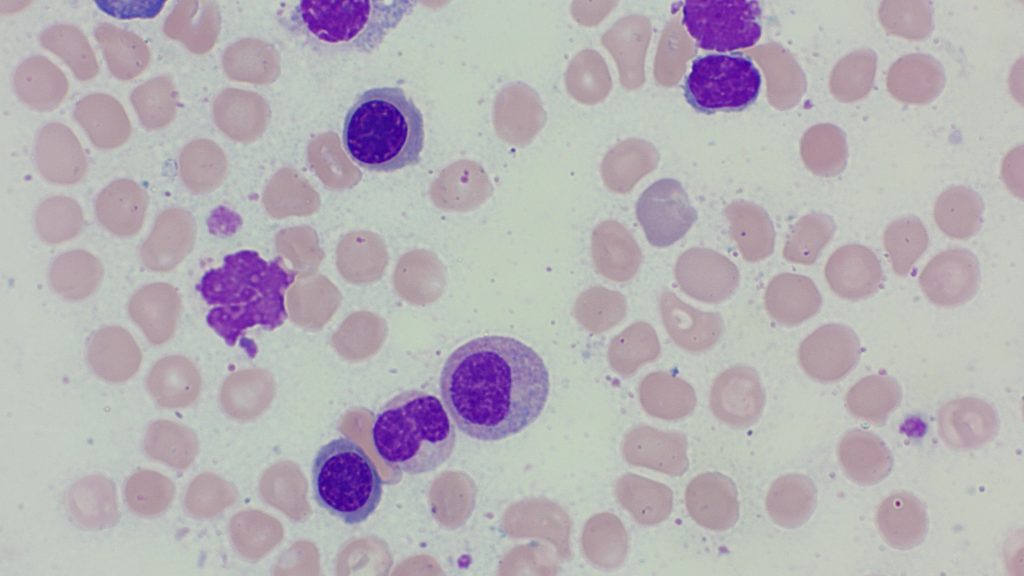
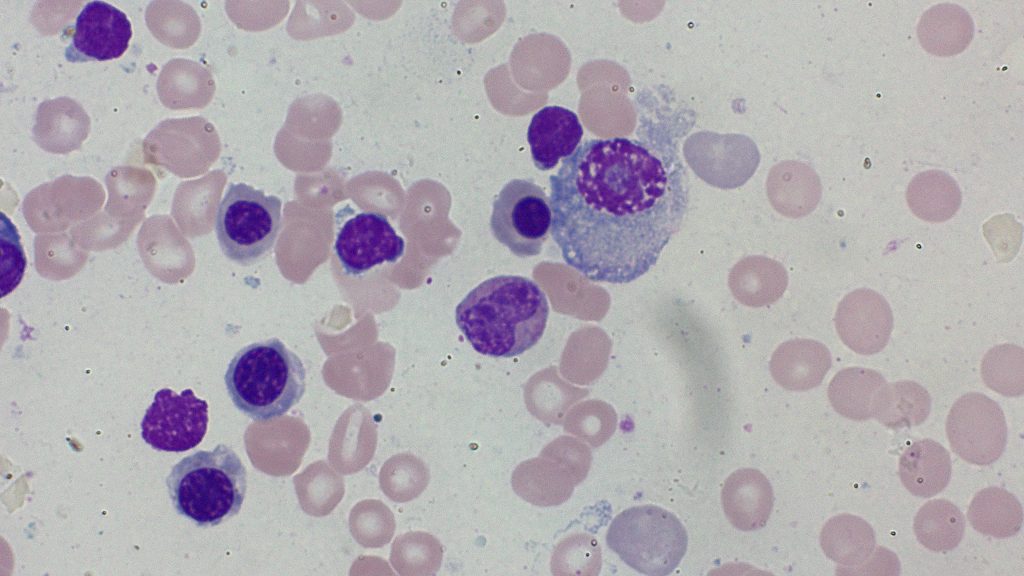
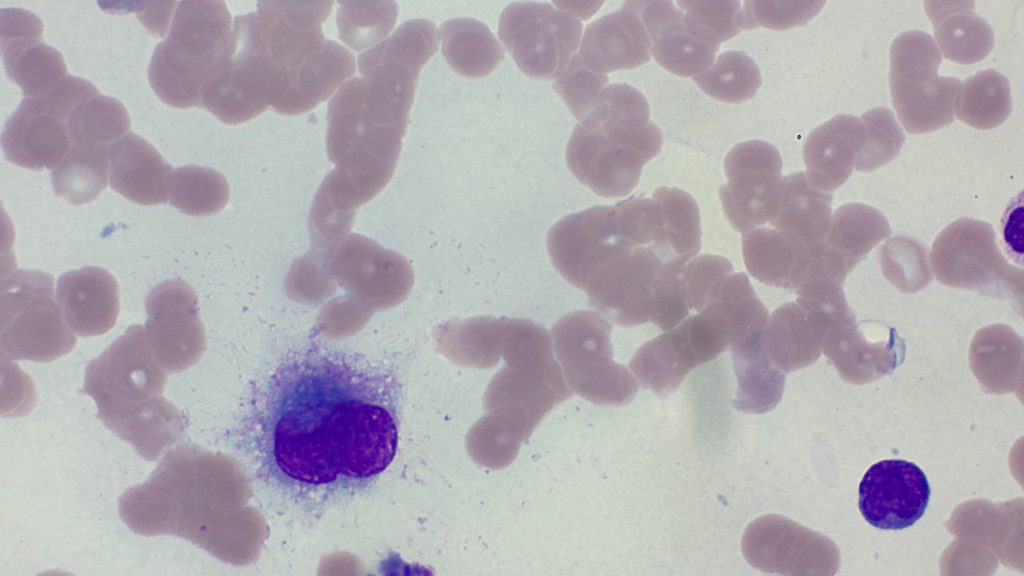
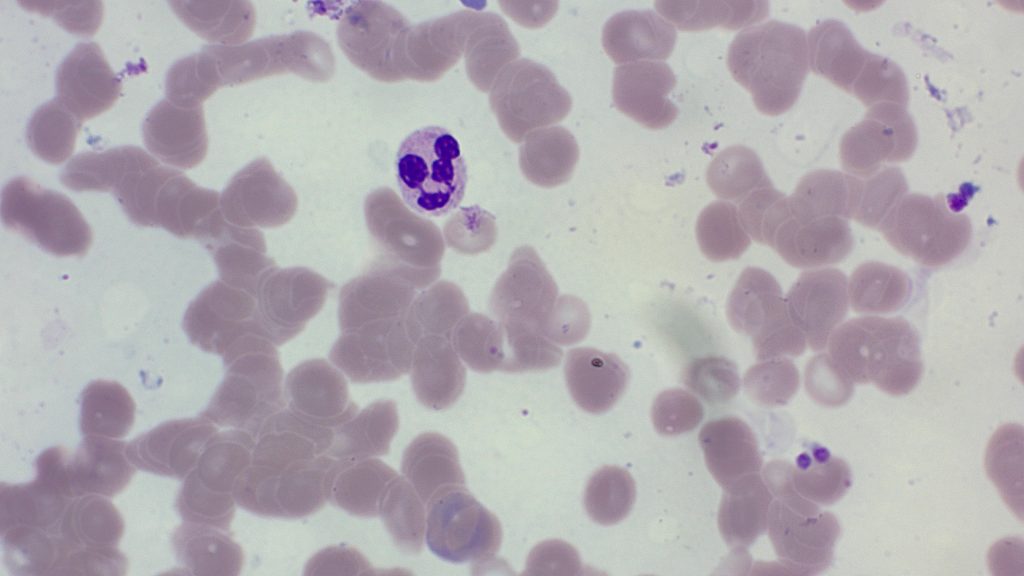
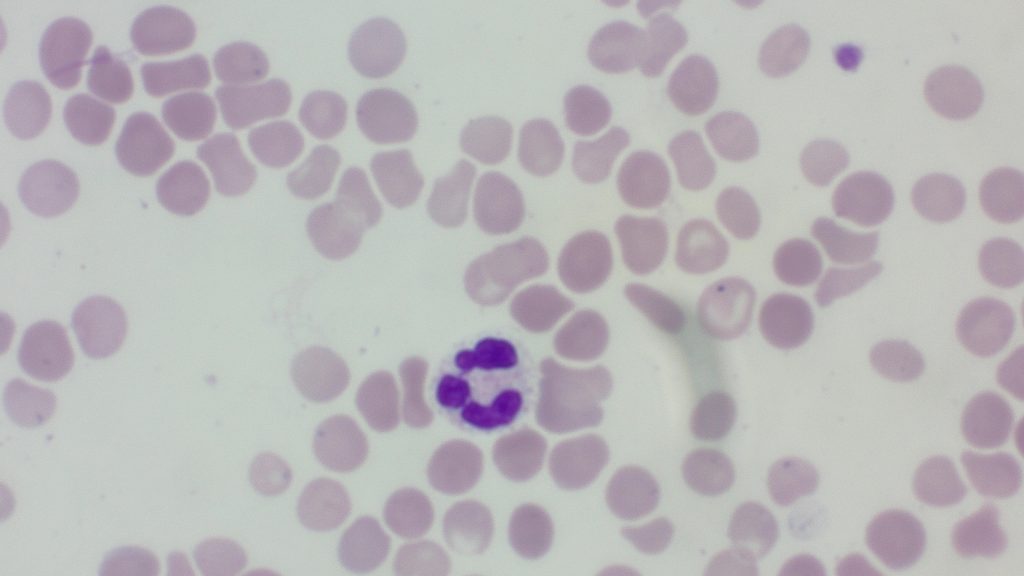
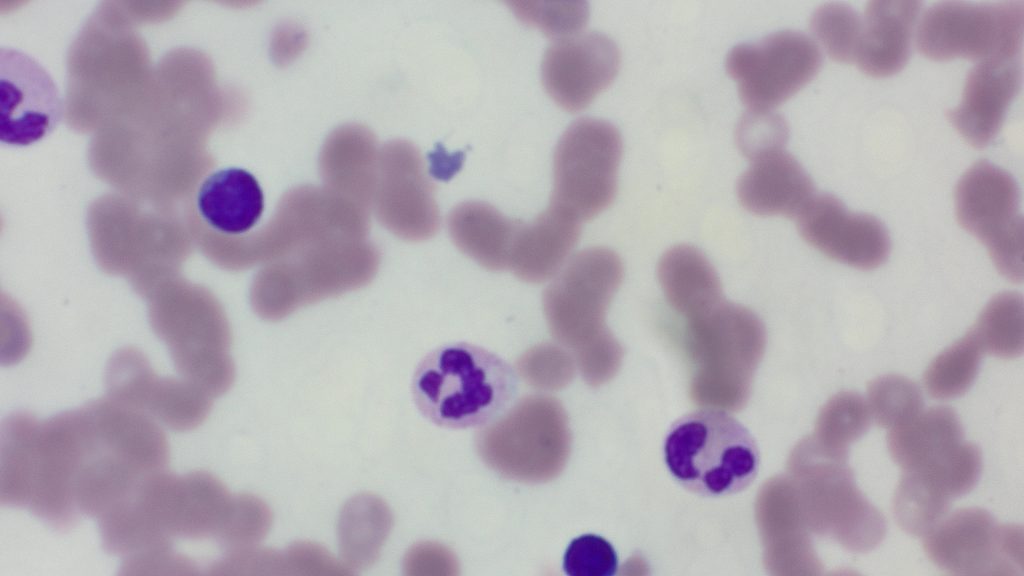
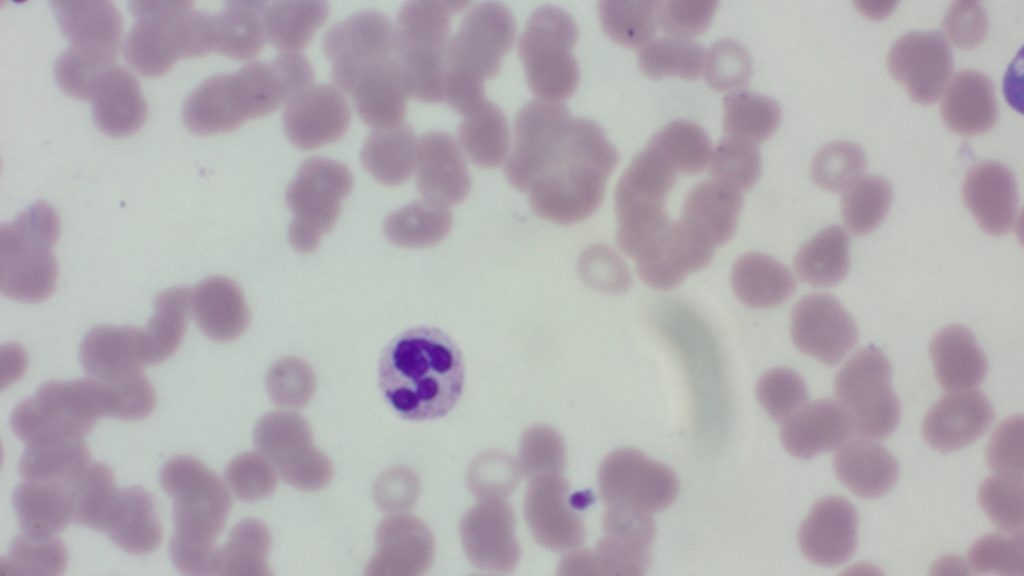
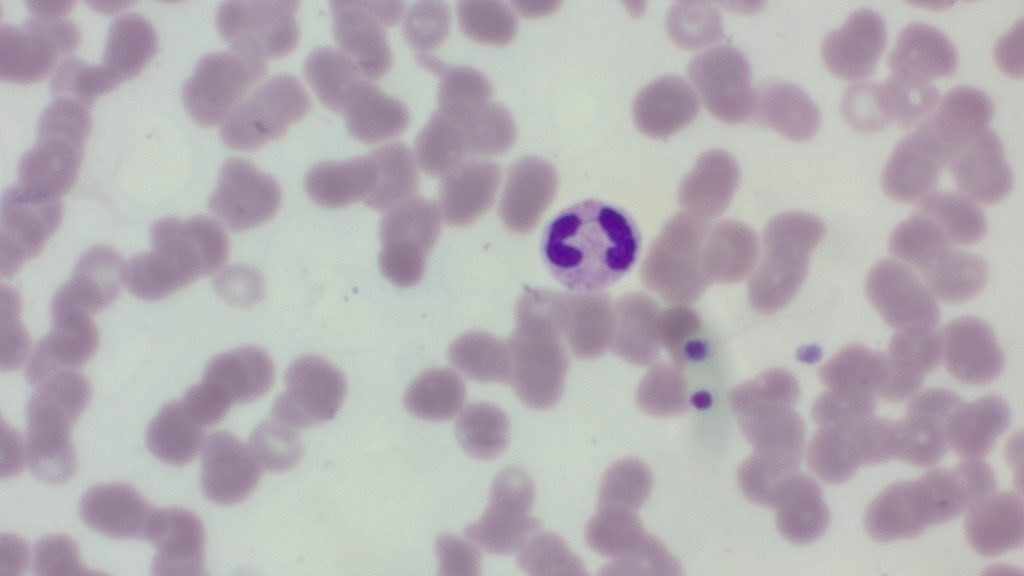
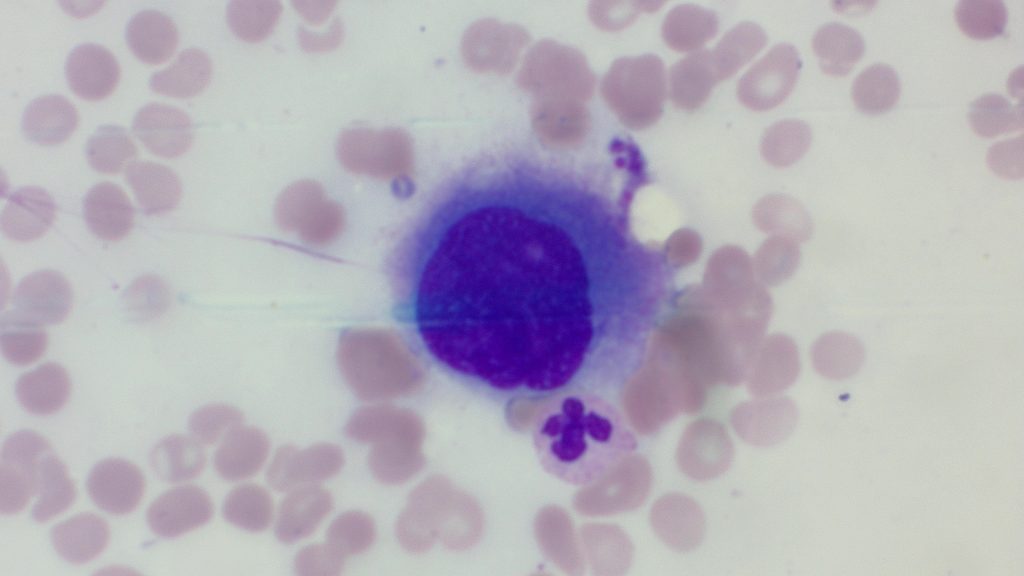
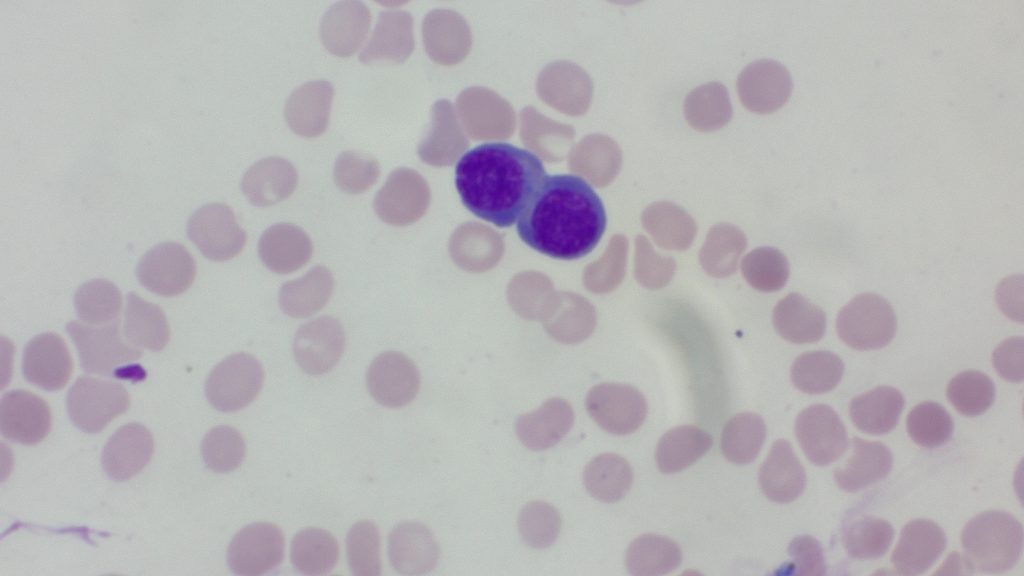
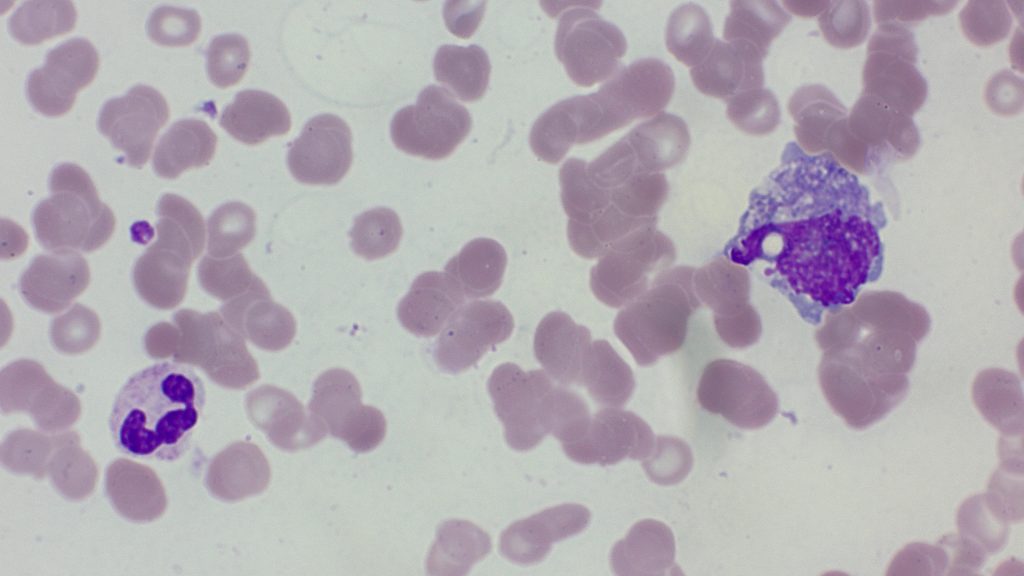
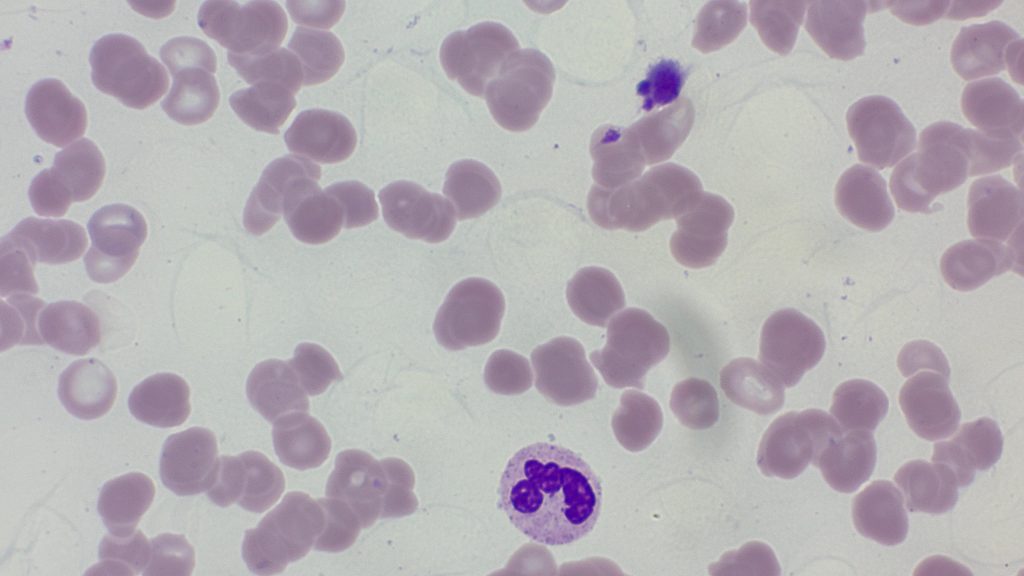
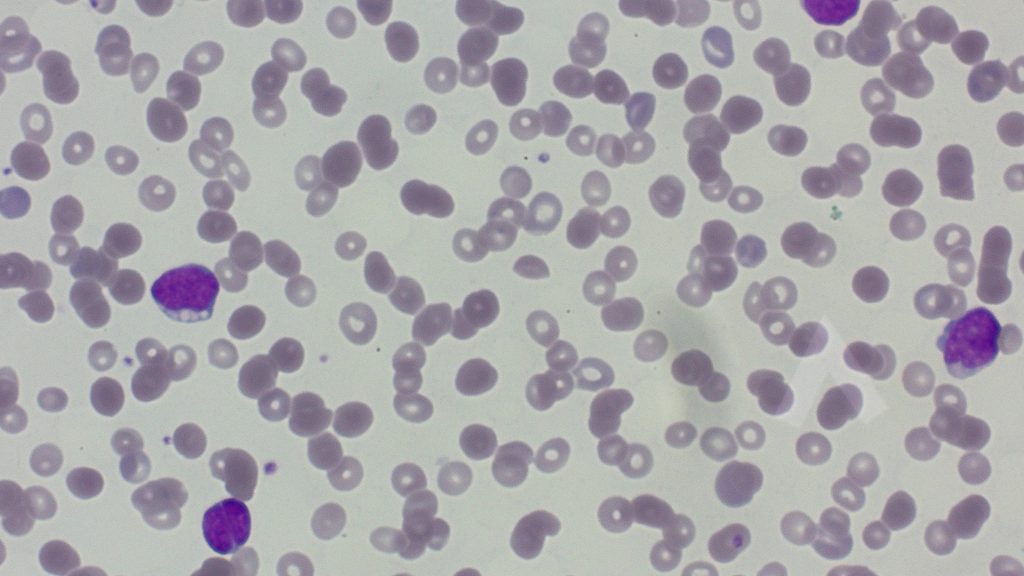
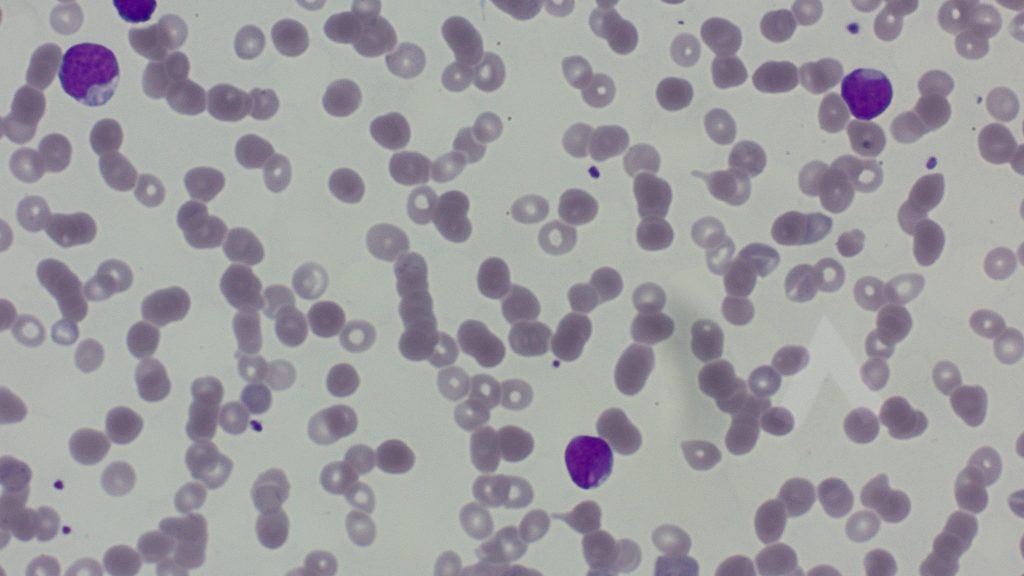
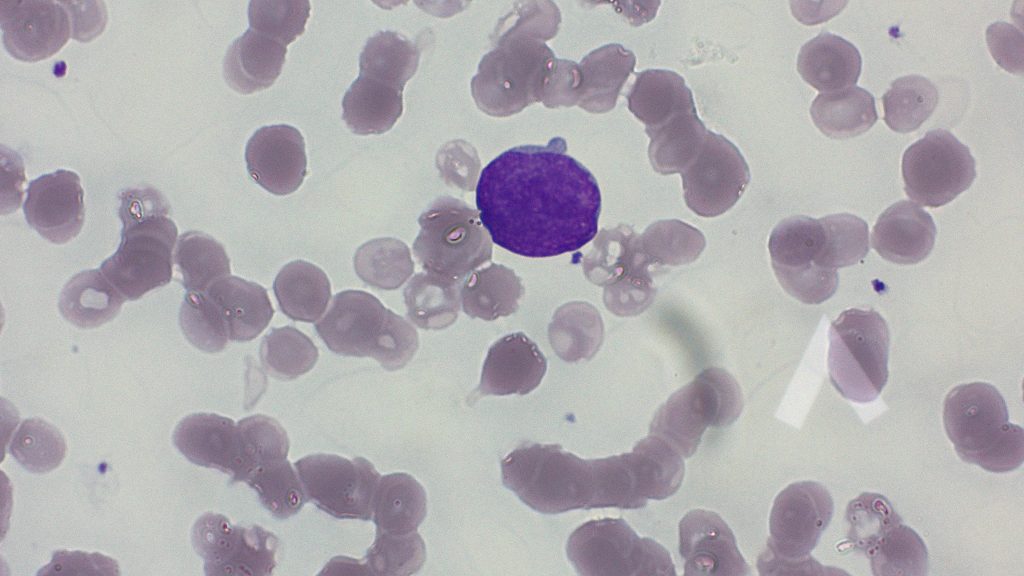
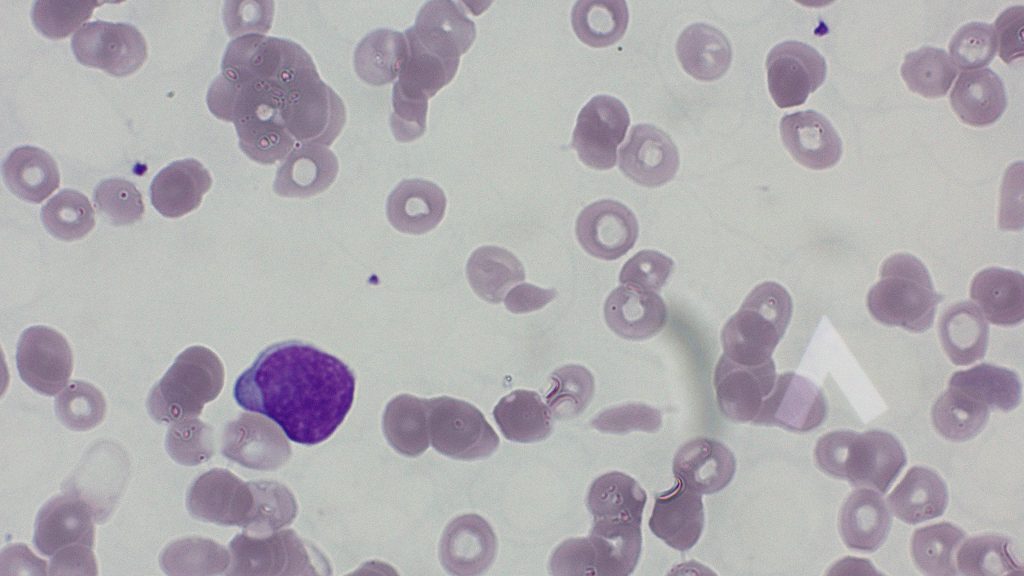
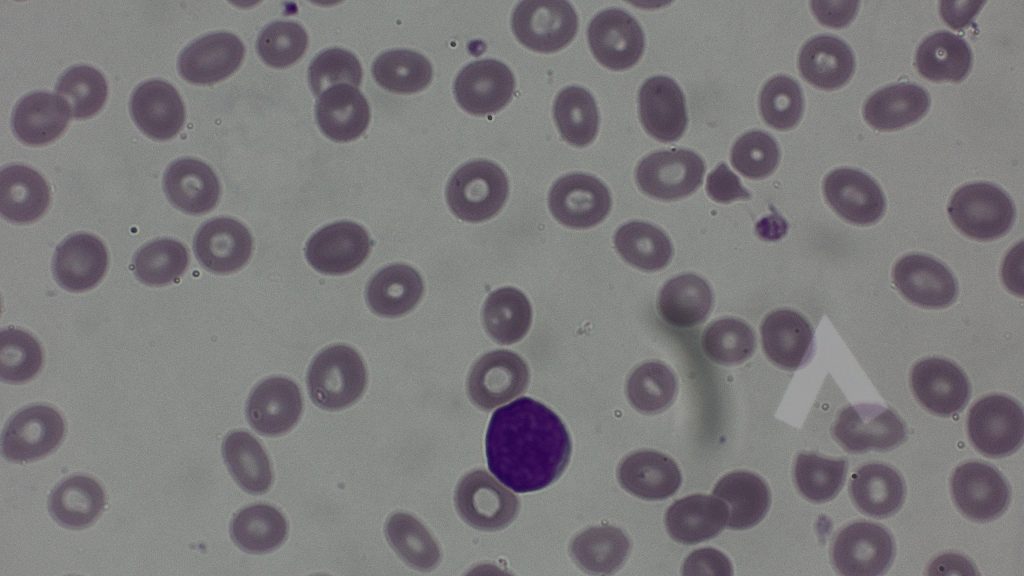
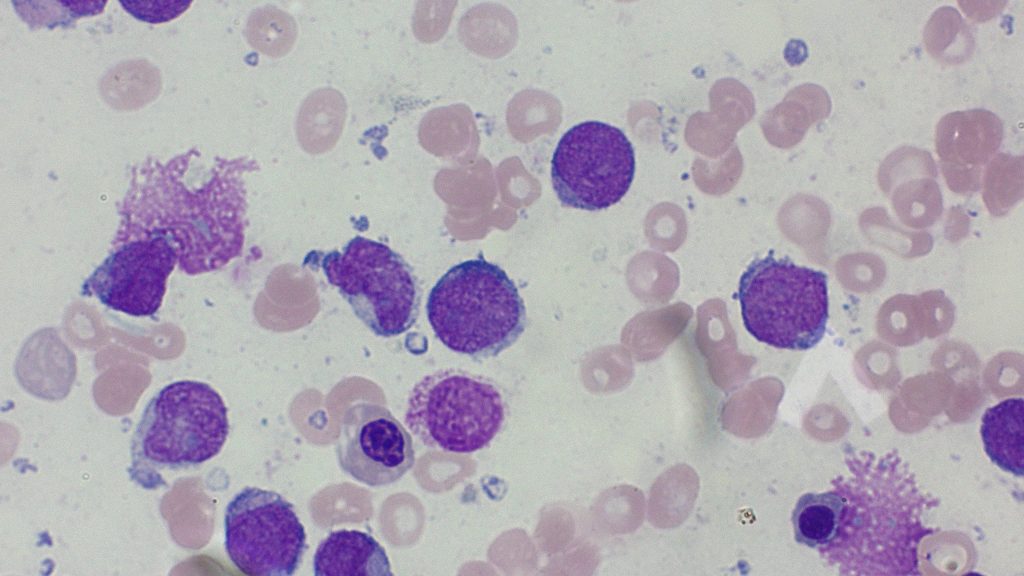
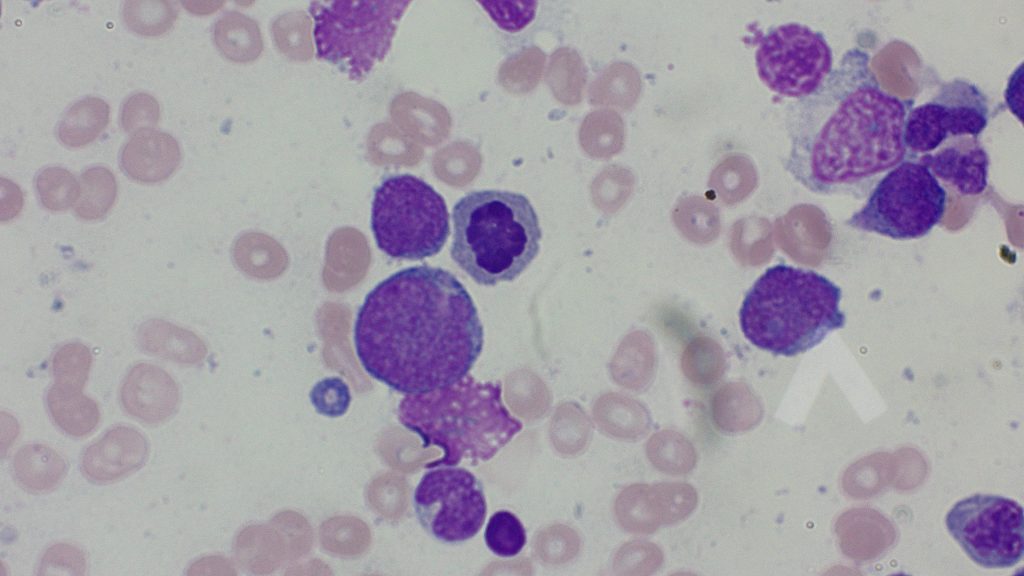
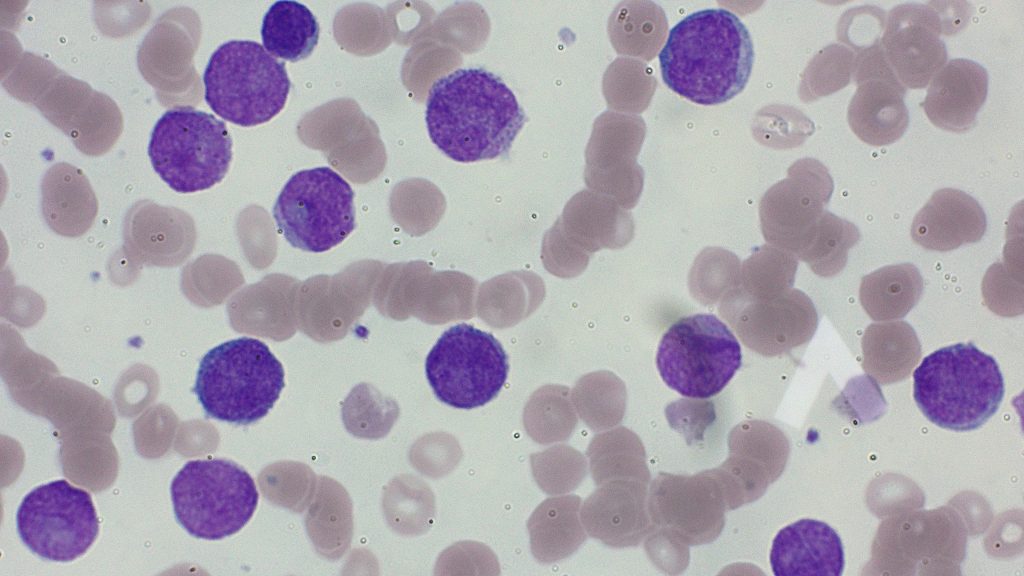
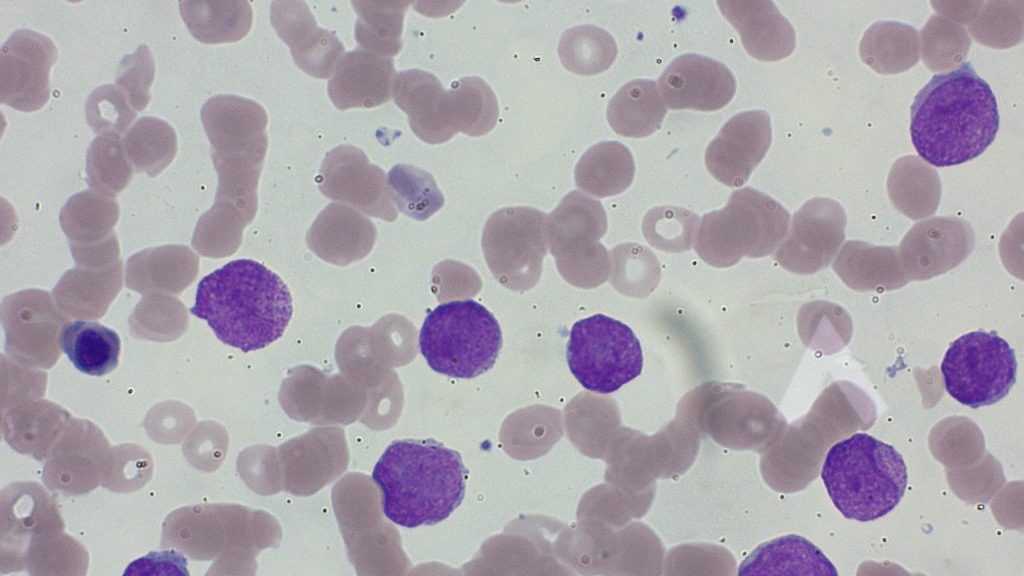
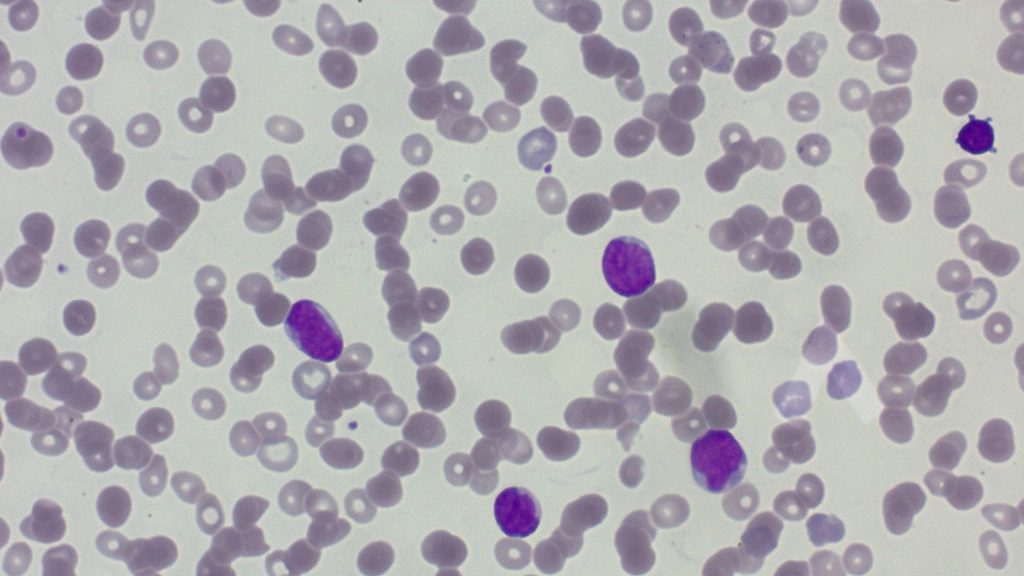
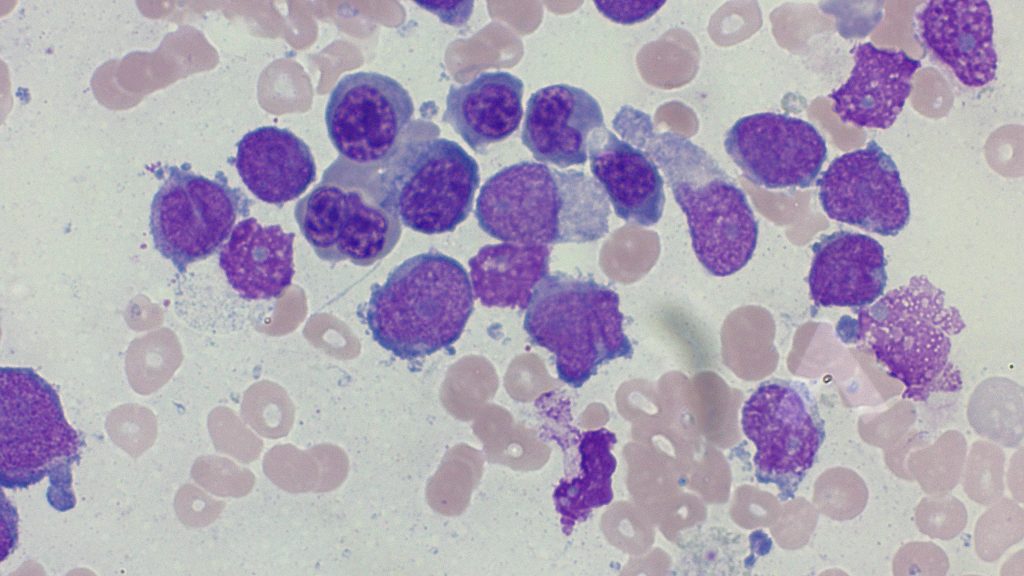
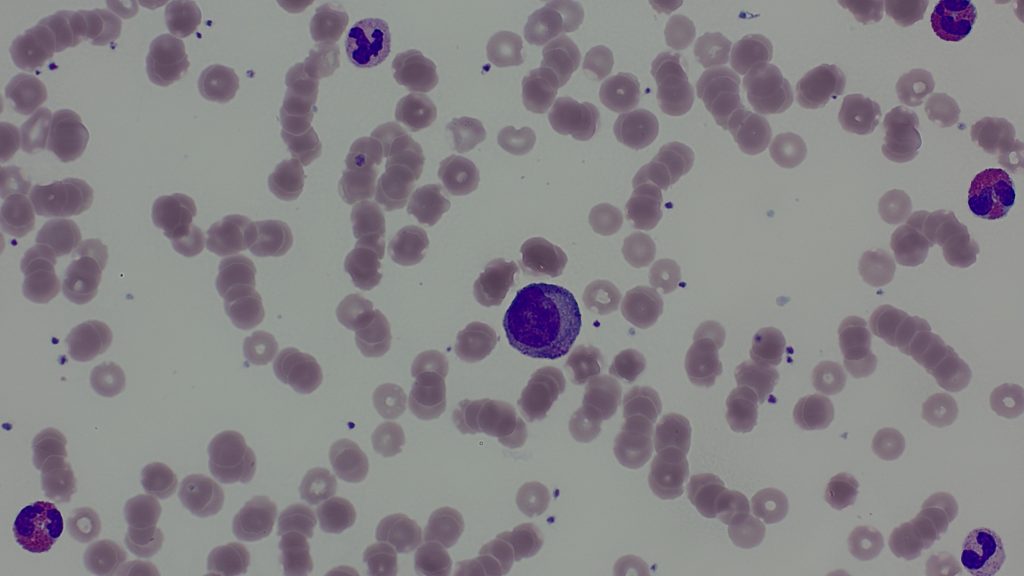
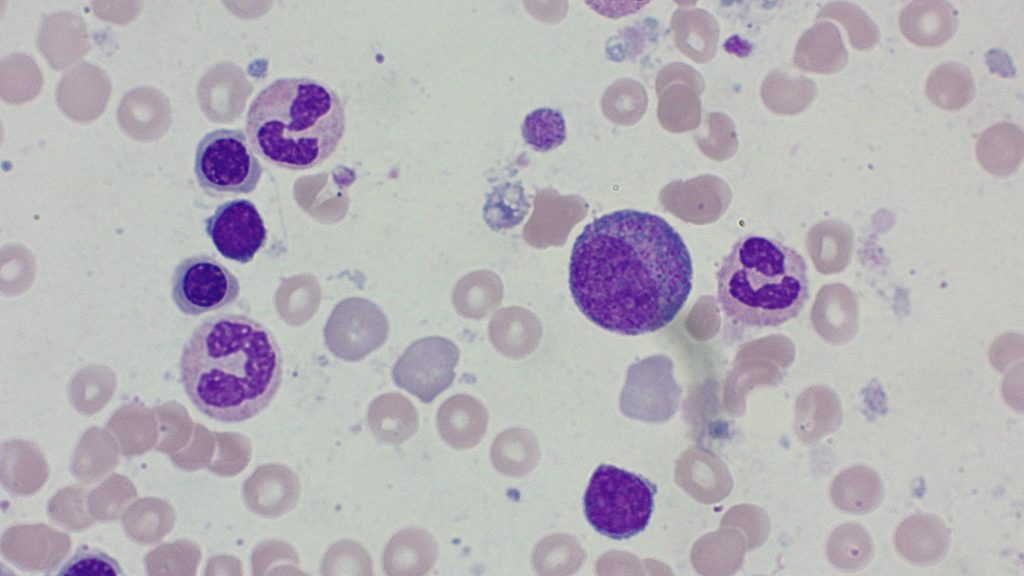
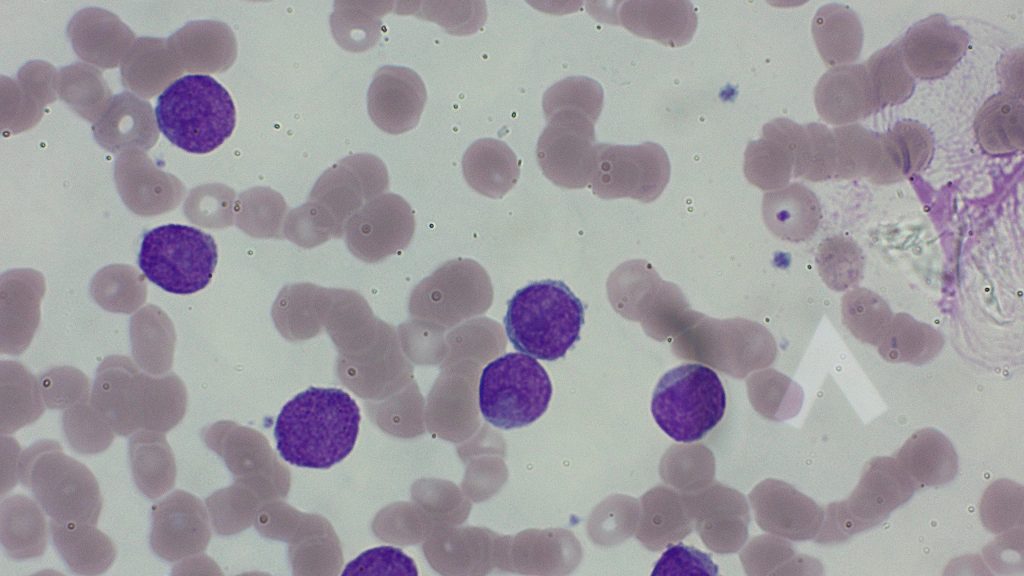
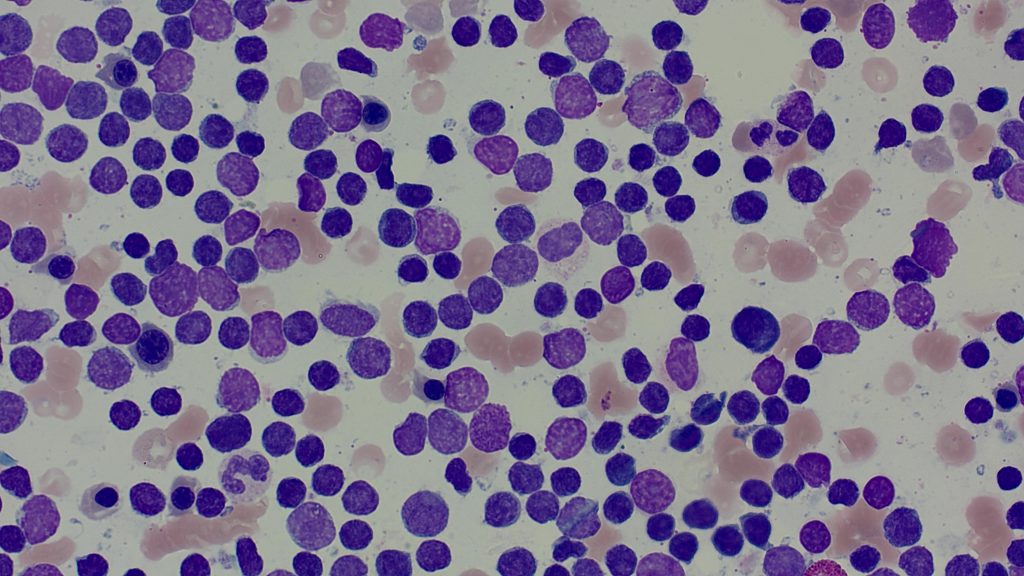
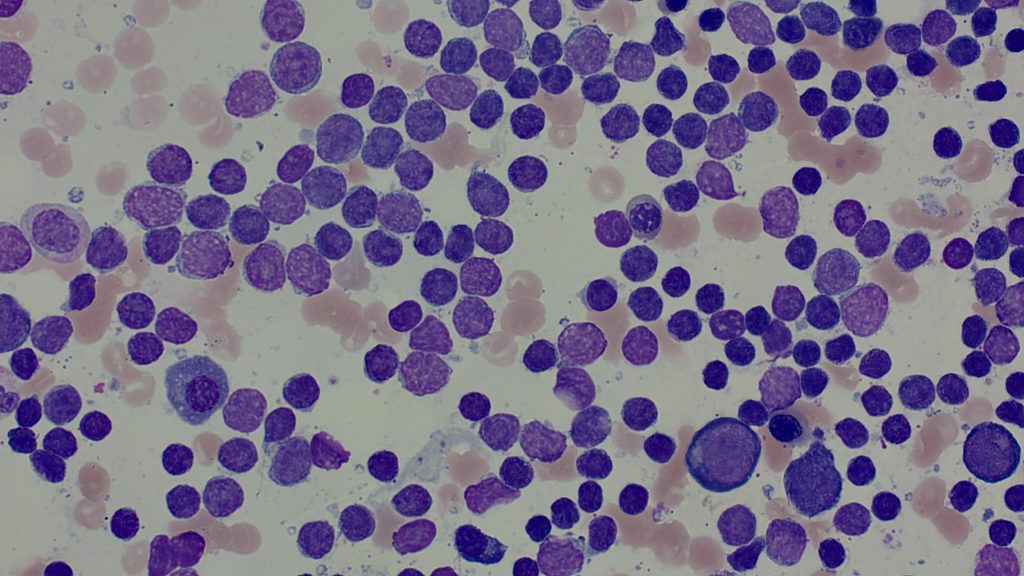
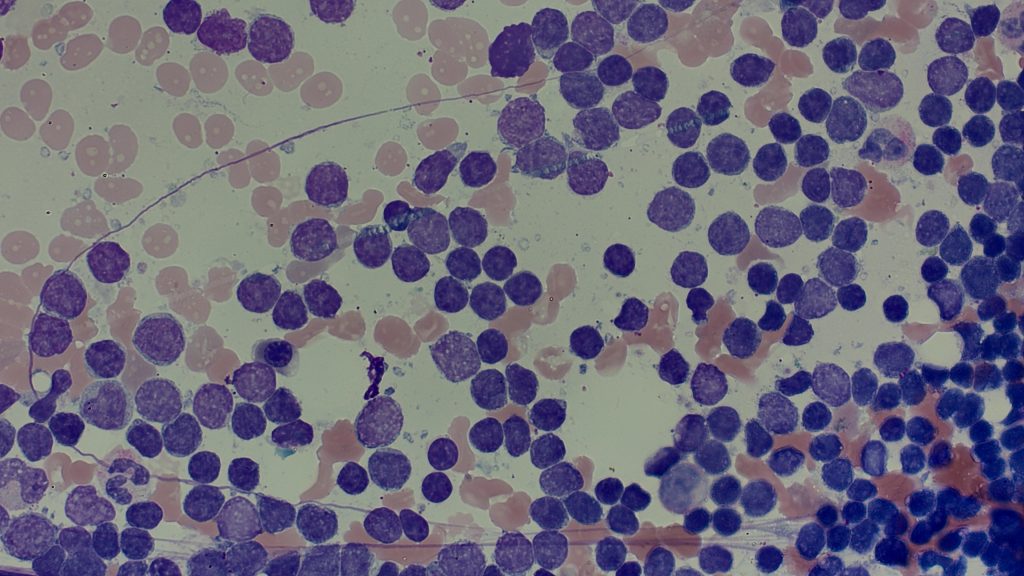
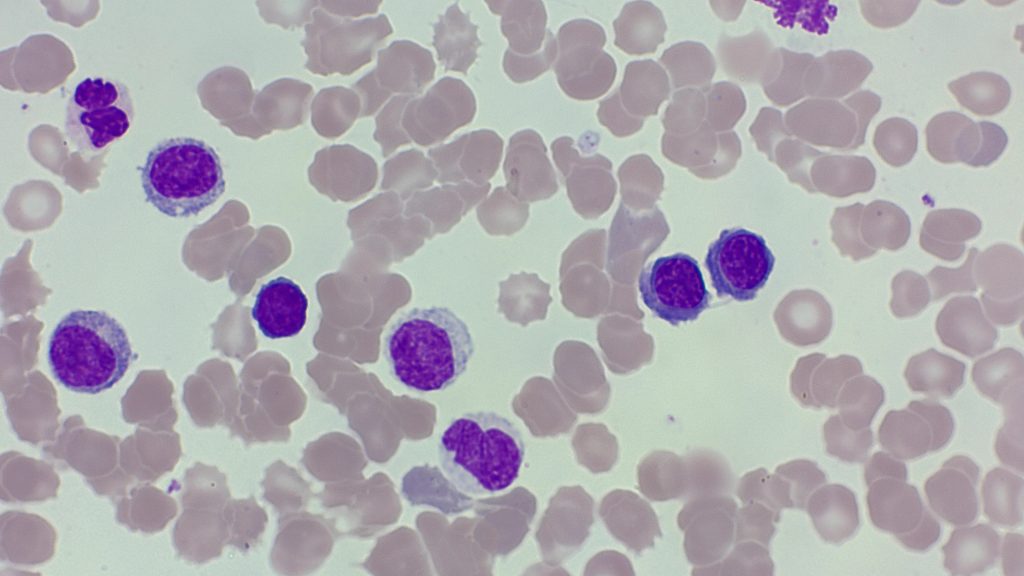
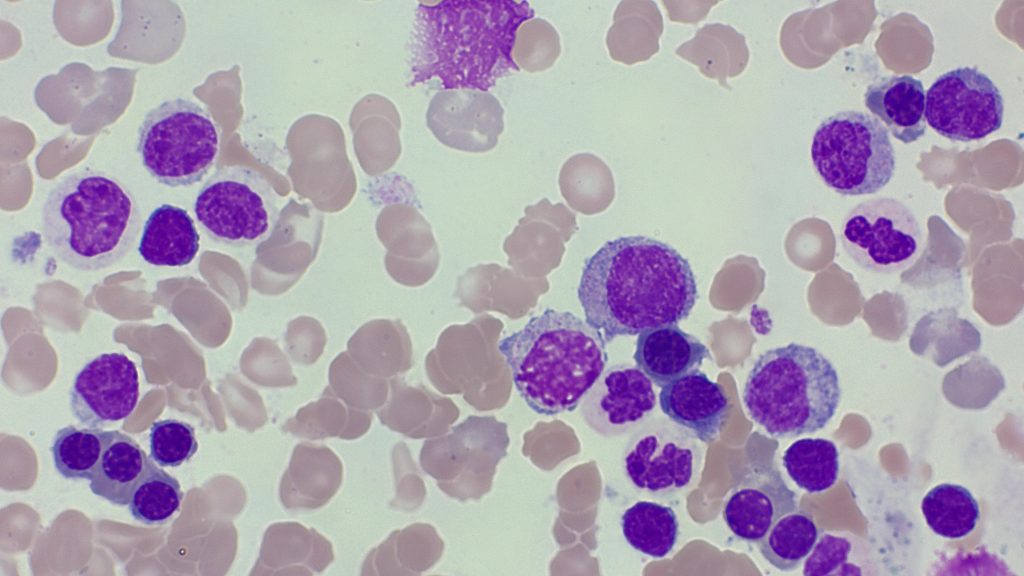
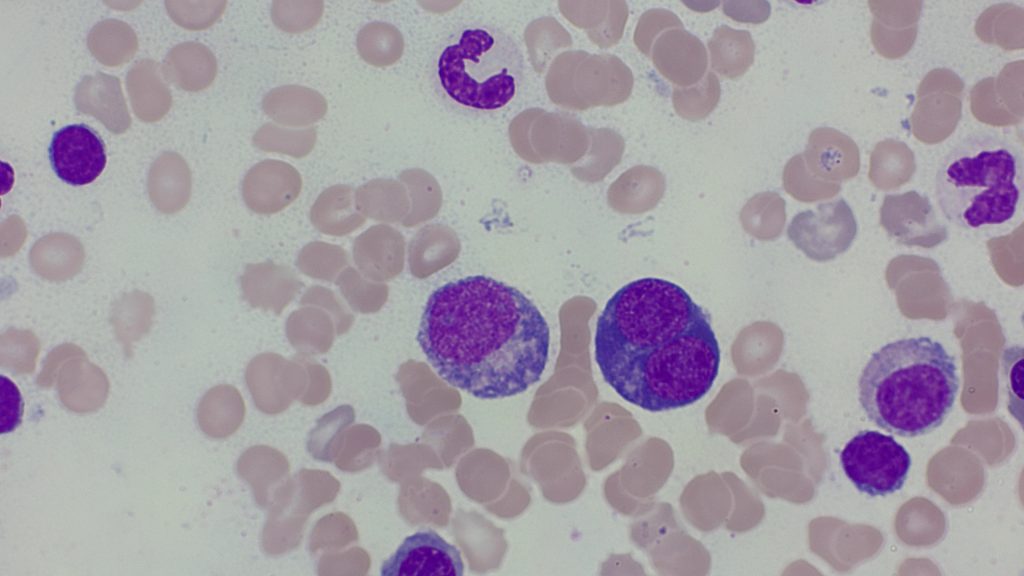
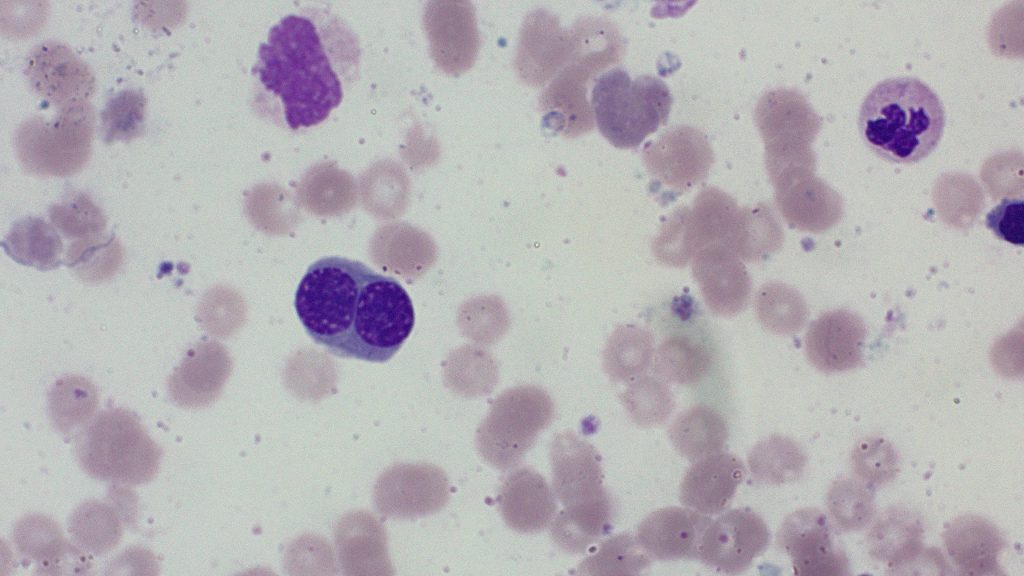
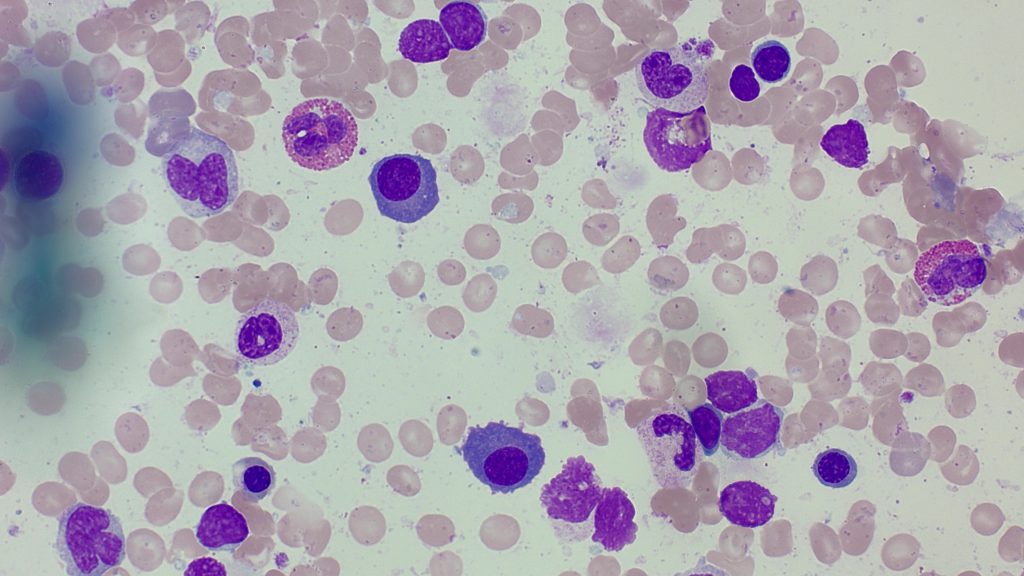
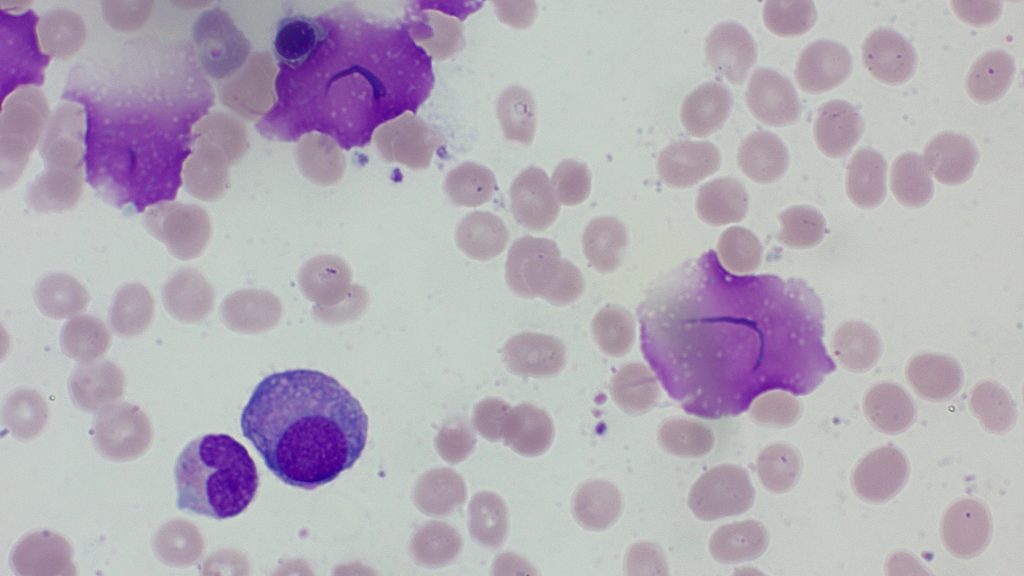
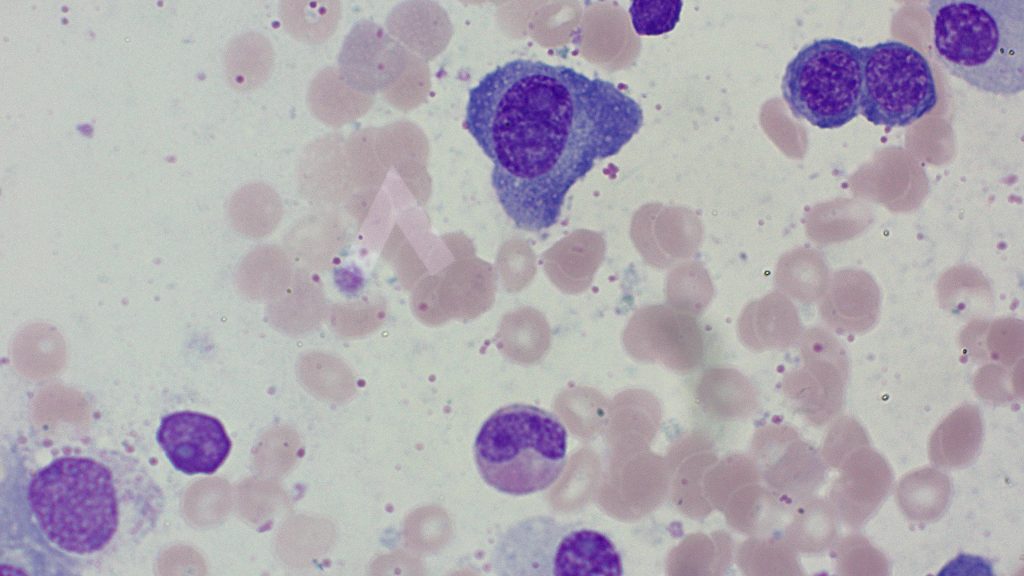
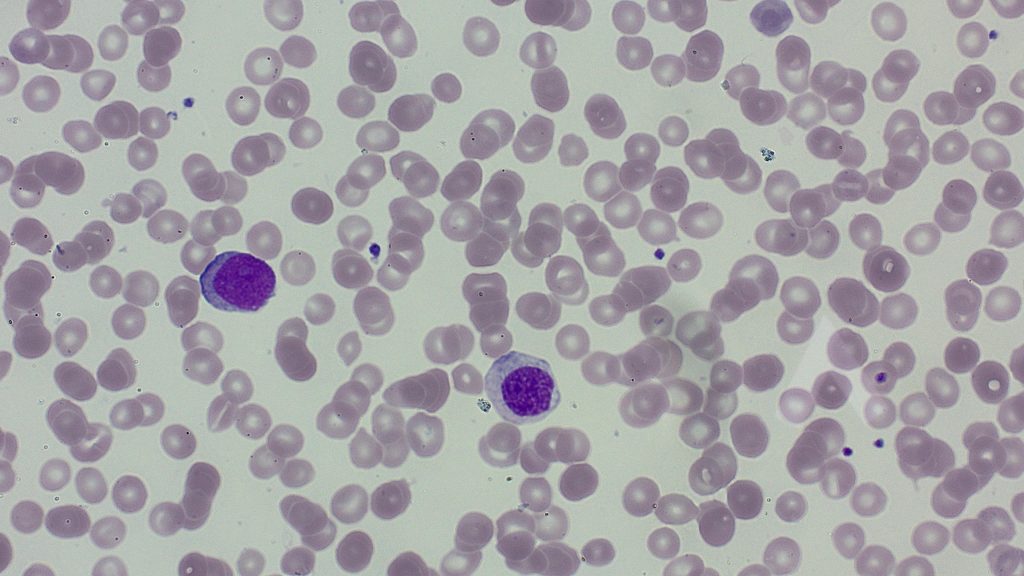
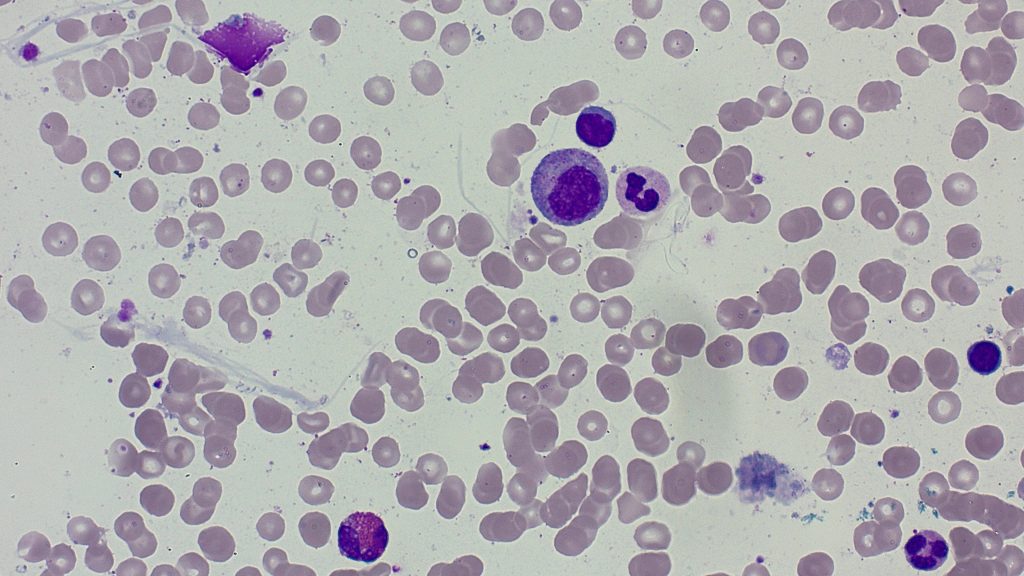
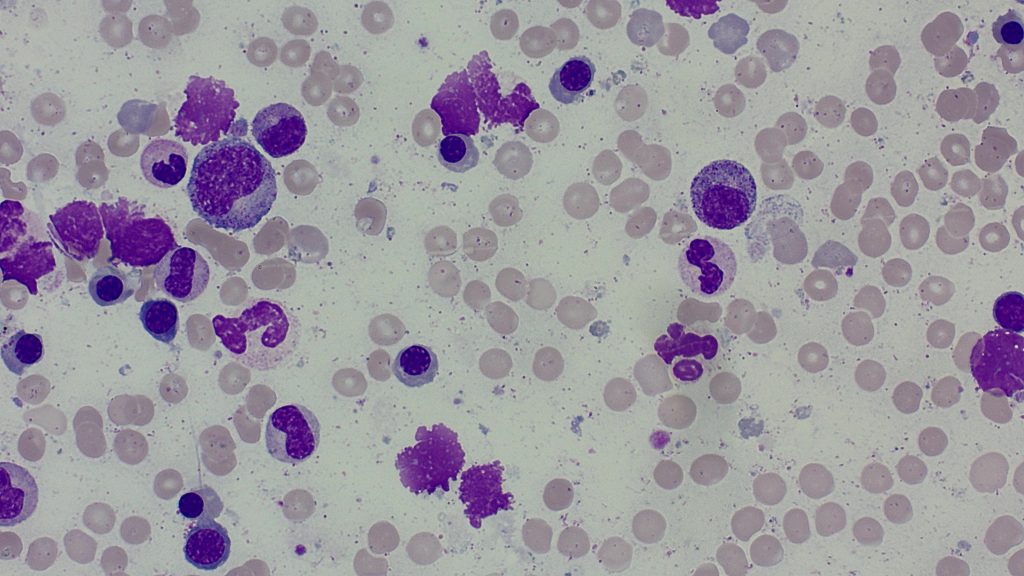

Discover my self made gallery.




Categories
Click the Buttons to discover the Categories
AMML
Click me

Basophils
Click me


















































Eosinophils
Click me
























































































Erythrocytes
Basophilic stippling






Binucleated erythrocytes









































Dysmorphic nuclei

Erythropoiesis

Iron staining










Megaloblasts







































Oval nuclei








Hemophagocytosis
Click me
















Histiocytes
Click me

Leukocytes
Band

Metamyelocyte





Myeloblast

Neutrophils


Promyelocyte

Band
Click me

Metamyelocyte
Click me

Megakaryocytes
Abnormal cytoplasm















Micromegakaryocytes

























Separated nuclei









Hypolobated nuclei























More…















































































































































































Multiple Myeloma
Dohle bodies














Intranucleolar inclusions




Multiple nuclei

Myeloma Cells

More…


Myelocyte
Click me

Myelofibrosis
Click me














